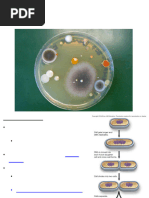

0% found this document useful (0 votes)
25 views40 pagesMicrobial Growth and Cultivation
Microbial growth occurs through reproduction by binary fission or budding. Bacteria grow in four stages in a batch culture: lag phase, exponential growth phase, stationary phase, and death phase. Growth is measured through cell counts, colony counts, turbidity, or mass determination. Bacteria require carbon, nitrogen, inorganic ions, and sometimes growth factors for growth. Temperature, pH, salt concentration, and availability of nutrients and oxygen influence microbial growth rates.
Uploaded by
Luke Jovanni TAOCCopyright
© © All Rights Reserved
We take content rights seriously. If you suspect this is your content, claim it here.
Available Formats
Download as PDF, TXT or read online on Scribd
0% found this document useful (0 votes)
25 views40 pagesMicrobial Growth and Cultivation
Microbial growth occurs through reproduction by binary fission or budding. Bacteria grow in four stages in a batch culture: lag phase, exponential growth phase, stationary phase, and death phase. Growth is measured through cell counts, colony counts, turbidity, or mass determination. Bacteria require carbon, nitrogen, inorganic ions, and sometimes growth factors for growth. Temperature, pH, salt concentration, and availability of nutrients and oxygen influence microbial growth rates.
Uploaded by
Luke Jovanni TAOCCopyright
© © All Rights Reserved
We take content rights seriously. If you suspect this is your content, claim it here.
Available Formats
Download as PDF, TXT or read online on Scribd